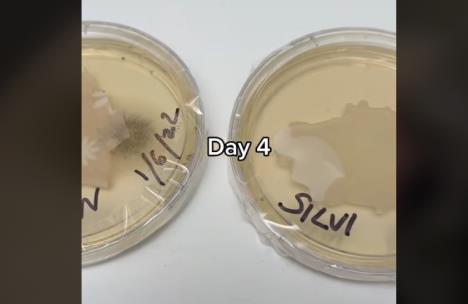
posteljina.jpg

URADIO TEST, PA OSTAO ZAPREPAŠĆEN: Pogledajte koliko BAKTERIJA se razvije na pamučnim, a koliko na SVILENIM jastučnicama! VIDEO
Poslednjih nekoliko godina veliku popularnost kod odabira posteljine stekle su svilene jastučnice, a mnoge studije su pokazale da imaju višestruke prednosti u odnosu na pamučnu posteljinu.
Pamučne jastučnice većini su prvi izbor prilikom odabira posteljine. Međutim, postoje određene prednosti koje koži vašeg lica i kosi daju satenske i svilene jastučnice, a pamučne zbog svog sastava to nisu u mogućnosti.
Prava svila sastoji se od vlakna životinjskih proteina određenih insekata koji imaju sposobnost izrade svojih ljuštura i mreža. Iako sam opis ne zvuči najprivlačnije, svila je tkanina koja diše te jedna od najmekanijih i najudobnijih tkanina, ali i najcenjenijih.

Kada se radi o odabiru jastučnice, i svila i saten imaju jednake benefite za vašu kosu i kožu. Zbog svoje ugodne, mekane i glatke teksture jako su zahvalan materijal za površinu kože i kosu.
Ako imate problema sa zapetljanom kosom, na svilenim ili satenskim jastučnicama vaše će vlasi imati manje šanse da se zapetljaju jer ne "zapinju" kao na pamučnim jastučnicama. Takođe, ove tkanine čuvaju kosu od ispucalih vrhova, ali i sprečavaju nastanak akni.
Na TikToku je nedavno osvanuo video koji pokazuje koliko se bakterija za nedelju dana razvije na pamučnim jastučnicama u odnosu na svilene.
Video je skupio preko 12 miliona pregleda. Dok jedni tvrde da je reč samo o dobrom marketingu, drugi se kunu u brojne benefite spavanja na svilenim jastučnicama.
(Kurir.rs/Klix.ba)



